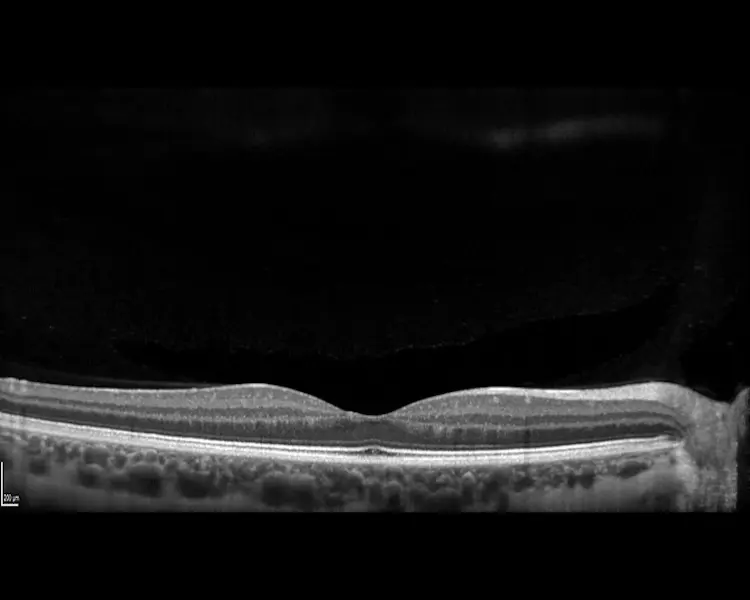

Our Pricing
Please find below a list of our fees. Pricing relates to our privately owned clinic in Portsmouth (Prema). When seen in different hospitals/clinics, facility fees may vary. Please check external websites for accurate pricing.
All prices for surgery are quoted per eye. Should the procedure you require not be listed, please contact a member of the patient support team, and they will gladly assist you.